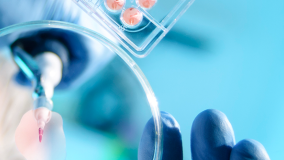
A scientist using a pipette with a microtiter plate and a petri dish

Regulatory Considerations for Delivering ATMP Multi-Model Facilities
With the emergence of new medical treatments and therapies reaching the market, and thousands of new therapies also in preclinical and clinical stages, pharmaceutical manufacturing companies are looking to implement multi-model and flexible facilities. Jacobs’ Julie Vickers, Todd Rumsey, Peter Cramer and Francesca McBride discuss how to determine compatibility and congruence between primary and alternative modalities to deliver products with different manufacturing requirements and deliver transformative medicines to patients, faster.
View more
The Burbank-Glendale-Pasadena Airport Authority Soars in Style: Paves Way for New Passenger Terminal
Heralding a new era in air travel, The Burbank-Glendale-Pasadena Airport Authority rolled out the red carpet to celebrate the glamorous 94th anniversary of Hollywood Burbank Airport on May 30, 2024! With this celebration, officials sealed the deal on $724.78 million in 2024 Airport Revenue Bonds, which were issued through an underwriting syndicate led by BofA Securities with Public Resources Advisory Group serving as the Authority’s municipal advisor. The bonds are paving the way for a brand-new, state-of-the-art passenger terminal that will be 355,000-square-feet and include a 14-gate terminal that promises to redefine the airport experience for millions of travelers. Get a look at how we’re taking Hollywood Burbank Airport to new heights in this article.
View more

9020.jpg)













2c4e.jpg)


















_0ac2b.jpg)









2747.png)














